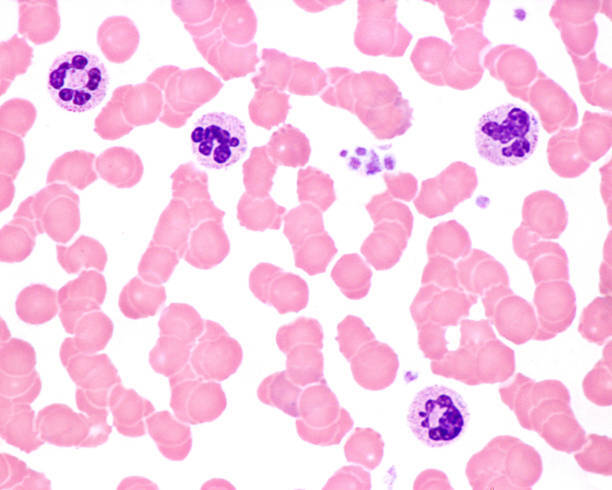
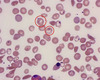
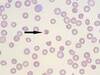
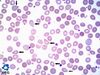

Mieloma Múltiplo:
Definição
- como pode aparecer em prova a hipergamaglobulinemia?
Rastreamento
- qual o exame e qual o achado?
Eletroforese de proteínas séricas normal exclui o diagnóstico?
E o diagnóstico definitivo? (2)
Qual o tipo de anticorpo proliferado mais comum?
Definição: Neoplasia que cursa com proliferação de plasmócitos e hipergamaglobulinemia MONOCLONAL.
Anticorpos idênticos, pois provêm de um mesmo clone.
- pode aparecer em prova como inversão na relação albumina/globulina
Rastreamento:
Eletroforese de proteínas séricas e/ou urinárias:
Componente M >= 3 ou Paraproteína M
- gamopatia monoclonal
Eletroforese de proteínas séricas normal exclui o diagnóstico?
Não, pois existe um subtipo de mieloma múltiplo com aumento de cadeias leves, que só é visualizado em eletroforese de proteínas URINÁRIAS.
Como pode-se encontrar a Hipergamaglobulinemia
- pode aparecer em prova como inversão na relação albumina/globulina
E o diagnóstico definitivo?
1. Biópsia de Medula Óssea: >= 10% Plasmócitos
ou
2. Plasmocitoma
Qual o tipo de anticorpo proliferado mais comum? IgG
Mieloma Múltiplo:
Manifestações clínicas / laboratoriais:
Quais são? (5)
- por que ocorrem?
Qual o marcador inflamatório laboratorial aumentado?
- Anemia
- pode ocorrer pro doença crônica
- pode ocorrer por invasão medular e aplasia - Lesões líticas ósseas
- ocorre por ativação de osteoclastos - Hipercalcemia
- ocorre por aumento na reabsorção óssea - Insuficiência renal
- etiologia multifatorial:
a. deposição de cadeias leves
b. proteinúria de Bence-Jones
c. aumento da uricosúria
d. nefrocalcinose
e. amiloidose
- MM é a principal causa de amiloidose SECUNDÁRIA - PREDISPOSIÇÃO À INFECÇÕES
- ocorre porque não há produção de anticorpos normais, que não aqueles que provêm do clone neoplásico
Qual o marcador inflamatório laboratorial aumentado?
VHS
Qual a alteração laboratorial encontrada?
Quando costuma ocorrer?
Qual a doença mais associada na hematologia?

Qual a alteração laboratorial encontrada?
ROULEAUX (empilhamento de hemácias, como moedas).
Quando costuma ocorrer?
Quando há aumento de proteínas plasmáticas.
Qual a doença mais associada na hematologia?
Mieloma Múltiplo.
Quais neoplasias mais associadas ao surgimento de lesões ósseas líticas? (3)
- Mama
- Pulmão
- principalmente Epidermoide pelo surgimento de PTHrP - Mieloma múltiplo
Mieloma Múltiplo:
Como fazer a confirmação diagnóstica? (2)
Sempre tratar?
Atividade de doença clínica que indica tratamento
- macete CARRO
Qual o tratamento?
- há cura?
- primeira e segunda fase
Qual o marcador de estadiamento e prognóstico?
Como fazer a confirmação diagnóstica?
1. >= 10% Plasmócitos na MO
ou
2. Plasmocitoma
Sempre tratar?
Não, tratamento envolve imunossupressão. Os benefícios devem superar os riscos e, portanto, tratamos aqueles com repercussões clínicas ou laboratoriais específicas.
Não tratar os chamados Smoldering Mieloma ou Mieloma Indolente.
Atividade de doença clínica que indica tratamento:
C = Calcemia > 10,5/11
A = Anemia com Rouleaux (Hb < 10)
R = Rim (BENCE JONES, amiloidose, síndrome de lise tumoral, Cr > 2, ClCr < 40)
R = Recorrente (imunossupressão e infecções)
O = Ossos (lesões líticas)
Qual o tratamento? Não há cura
1. Primeira fase:
Corticoide + Imunomoduladores ou QT por 3-4 meses
2. Segunda fase:
Transplante autólogo de MO
Estadiamento e prognóstico:
B2-Microglobulina
Anemia Ferropriva:
Epidemiologia
Índices Hematimétricos - como se encontram?
- VCM | HCM | RDW | Reticulócitos
Qual a alteração que pode ocorrer com as plaquetas?
Epidemiologia: principal causa de anemia no mundo.
Índices Hematimétricos:
1. VCM < 80 = MICROcitose
2. HCM < 28 = HIPOcromia
3. RDW > 14% = ANISOCITOSE
- variabilidade aumentada no tamanho das hemácias
4. Reticulócitos < 2% = hipoproliferativa / contagem de reticulócitos diminuída
Qual a alteração que pode ocorrer com as plaquetas?
Trombocitose
- pode ser bastante considerável
Anemia Ferropriva:
Sinética do Ferro - como se encontram?
- Ferritina | TIBC | Ferro sérico | Saturação de Transferrina
Por que ocorre aumento de PROTOPORFIRINA?
Sinética do Ferro:
1. Ferritina < 30 (VR: 30-100)
2. TIBC > 360 (VR: 250-360)
- aumento do transportador
3. Ferro sérico < 60 (VR: 60-150)
4. Saturação de transferrina < 10% (VR: 20-40%)
Por que ocorre aumento de PROTOPORFIRINA?
Pois o grupo HEME da hemoglobina é formado por: ferro + protoporfirina. Se há queda do ferro, há mais protoporfirina livre.
Anemia Ferropriva:
Qual a primeira alteração observada na Sintética do Ferro?
Por que isso ocorre?
Queda da Ferritina para valores < 30.
Ferritina é a forma de estoque do Ferro.
Há depleção dos estoques como primeira tentativa de compensação a falta de Ferro.
Valor de referência da Ferritina: 30-100.
Anemia Ferropriva:
Etiologias principais (6)
Vegetarianos tem maior risco de anemia ferropriva?
Etiologias:
1. Sangramento crônico
- principalmente de trato gastrointestinal
2. Doença celíaca
3. Ancilostomíase
4. Prematuridade e desmame precoce
5. Gestação
- aumento de demanda de ferro, pois há aumento do hematócrito em 30%
6. Hipermenorreia
Vegetarianos tem maior risco de anemia ferropriva?
Não, a incidência é a mesma que em população onívora.
Anemia Ferropriva:
Sintomas relacionados a anemias carenciais (2)
Sintomas clássicos de carência de ferro (4)
Sintomas relacionados a doenças carenciais, no geral:
1. Glossite
2. Quelite angular
Sintomas clássicos de carência de ferro:
1. Perversão alimentar ou PICA
2. Coiloníquia
3. Síndrome de Plummer-Vinson
- disfagia - presença de membrana esofágica
4. Esclera azulada
Como se chama essa alteração?
Em um contexto de anemia, quando podemos encontrá-la?
Qual outra alteração pode estar associada?

Como se chama essa alteração?
Quelite angular
Em um contexto de anemia, quando podemos encontrá-la?
É uma alteração característica das anemias carenciais, no geral.
Qual outra alteração pode estar associada?
Glossite
Como se chama essa alteração?
Em um contexto de anemia, quando podemos encontrá-la?
Quais outras alterações podem estar relacionadas?

Como se chama essa alteração?
Coiloníquia (unha em colher)
Em um contexto de anemia, quando podemos encontrá-la?
Característica da anemia FERROPRIVA.
Quais outras alterações podem estar relacionadas?
1. Perversão alimentar ou PICA
2. Síndrome de Plummer-Vinson
- disfagia - membrana esofágica
3. Esclera azulada
Anemia Ferropriva:
Tratamento:
Como fazer a reposição em adultos?
Como fazer a reposição em crianças?
Como avaliar resposta ao tratamento?
Quando tendem a normalizar os níveis de hemoglobina?
Qual a duração do tratamento?
Qual o objetivo terapêutico?
Como fazer reposição se bariátrica prévia?
Reposição de Sulfato Ferroso
- contém: 20% de Ferro Elementar (FE)
Adultos: 60 mg de FE ou 300mg Sulfato Ferroso/dia
Crianças: 4-6 mg/kg/dia de FE
Como avaliar resposta?
Contagem de Reticulócitos
- início com 4-5 dias de tratamento
- pico entre 7-10 dias de tratamento
Quando tendem a normalizar os níveis de hemoglobina?
6 semanas
O aumento inicia em 7-10 dias
Duração do tratamento:
6 meses a 1 ano
Qual o objetivo terapêutico?
Ferritina > 50
OBS: algumas referências pediátricas consideram a meta de Ferritina > 15, para encurtar alguns tratamentos.
Como fazer reposição se bariátrica prévia?
Iniciar com Sulfato Ferroso VO, apenas se falha: via parenteral.
Anemia de Doença Crônica:
Quais doenças crônicas relacionadas? (3)
Fisiopatologia
- por que a HEPCIDINA gera queda do Ferro sérico?
Quais doenças crônicas relacionadas?
- aquelas que liberam citocinas inflamatórias:
1. Infecciosas
2. Inflamatória
3. Neoplásicas
Fisiopatologia:
1. Liberação de citocinas pró-inflamatórias (TNF-alfa, IL-1, IL-6)
2. Aumento de HEPCIDINA
- produzida no hepatócito
- ela gera:
3. Queda na biodisponibilidade de ferro:
a. Aprisionamento em forma de Ferritina
- em forma de estoque de Ferro
b. Queda na transferrina
- queda no transportador de Ferro
c. Queda na Ferroportina
- responsável pela absorção intestinal de Ferro
Anemia de Doença Crônica:
Índices hematimétricos - como se encontram?
- VCM e HCM
Sinética do Ferro - como se encontram?
- Ferro sérico | Saturação de Transferrina | Ferritina | TIBC
Tratamento
- mais efetivo | usar eritropoietina?
Índices hematimétricos:
- mais comum:
1. Normocítica: VCM entre 80-100
2. Normocrômica: HCM entre 28-32
- pode se assemelhar aos da anemia ferropriva:
1. Microcítica: VCM < 80
2. Hipocrômica: HCM < 28
Sinética do Ferro:
1. Ferro sérico < 60
2. Saturação de Transferrina < 10% ou entre 20-40%
3. Ferritina > 100 ou normal
4. TIBC < 250 ou normal
Tratamento:
1. Tratar a causa de base
- mais efetivo
2. Eritropoietina (EPO)
- apenas casos selecionados
- pode aumentar risco cardiovascular
Anemia Sideroblástica:
Fisiopatologia
- o que ocorre com o valor do ferro sérico?
Principais etiologias (5)
Índices hematimétricos - como se encontram?
- VCM | HCM | RDW
Sinética do Ferro - como se encontram?
- Ferro sérico | Saturação de Transferrina | Ferritina
Diagnóstico:
- achados de: Aspirado de MO | Sangue periférico
Tratamento (2)
Fisiopatologia:
Falha na síntese do grupo heme da hemoglobina:
- QUEDA DA PROTOPORFIRINA
- na ausência de protoporfirina, há mais ferro sérico livre: AUMENTO DO FERRO
Principais etiologias:
1. Álcool
2. Chumbo
3. Deficiência de Cobre
4. Hereditária
5. Uso de Isoniazida ou Rifampicina
Índices hematimétricos - como se encontram?
1. Microcítica (VCM < 80)
- se álcool for a etiologia: macrocítica (VCM > 100)
2. Hipocrômica (HCM < 28)
3. RDW: alto (>14%), ou seja, ANISOCITOSE
Sinética do Ferro - como se encontram?
1. Ferro sérico: alto (VR: 60-150)
2. Ferritina: alta (VR: 30-100)
3. Saturação de Transferrina: normal VR: 20-40%)
Diagnóstico:
1. Aspirado de Medula Óssea (MO)
> 15% de Sideroblastos em anel
- não patognomônico, mas pode corroborar
2. Sangue periférico
Corpúsculos de Pappenheimer (LÂMINA NO FLASHCARD)
- achado quase patognomônico
Tratamento:
1. Tratamento da causa de base
2. Quelante de ferro (como, desferoxamina) para evitar depósitos do Ferro em excesso

Anemia Megaloblástica:
Fisiopatologia:
De quais vitaminas depende a formação de hemácias? (2)
Se há queda nas vitaminas, qual a consequência principal?
- por que ocorre macrocitose?
De quais vitaminas depende a formação de hemácias?
1. Ácido Fólico (Vitamina B9):
- que deve ser ativada em Ácido Folínico
2. Cobalamina (Vitamina B12):
- que é imprescindível para essa ativação
Se há queda do ácido fólico ou da cobalamina:
Ocorre anormalidade no amadurecimento nuclear e distúrbio na DIVISÃO CELULAR adequada.
As células ficam muito grandes = MEGALOBLASTOSE.
Consequentemente há aumento do VCM (> 100) e MACROCITOSE.
Anemia Megaloblástica:
Índices hematimétricos - como se encontram?
- VCM | HCM | RDW | Reticulócitos
O que ocorre com o hemograma?
Quando há hipovitaminose característica?
Por que ocorre aumento de LDH e Bilirrubina Indireta?
Índices hematimétricos:
1. VCM > 100
- ou seja, Macrocitose
2. HCM entre 28-32:
- ou seja, Normocromia
- hemácias estão grandes, mas a hemoglobina é normal
3. RDW elevado (> 14%)
- ou seja, Anisocitose
4. Reticulócitos < 2%
- anemia do tipo hipoproliferativa
O que ocorre com o hemograma?
Há PANCITOPENIA, mas geralmente é um achado sem repercussões clínicas.
Quando há hipovitaminose característica?
- Cobalamina < 200
- Folato < 10
Por que ocorre aumento de LDH e Bilirrubina Indireta?
Apesar da Megaloblástica não ser agrupada com as anemias hemolíticas, a medula óssea entende a eritropoiese como INEFICAZ e gera hemólise, destruição dessas hemácias de tamanho aumentado.
Que achado está apresentado na imagem?
Quando ele ocorre?
A qual tipo de anemia está associado?
Que achado está apresentado na imagem?
Hipersegmentação de neutrófilos
- núcleos divididos de forma inadequada, por falha na divisão
Quando ele ocorre?
Quando há carência de ácido fólico (vitamina B9) ou cobalamina (vitamina B12)
A qual tipo de anemia está associado?
Anemia Megaloblástica
Anemia Megaloblástica:
Quais substâncias podemos dosar para corroborar com o diagnóstico? (2)
Por que ocorre o aumento de cada uma delas?
Qual substância acumulada é neurotóxica?
Quais as principais alterações neurológicas?
Qual a alteração neurológica típica de prova?
As alterações neurológicas são reversíveis?
Quais substâncias podemos dosar para corroborar o diagnóstico?
1. Homocisteína
- aumentada quando deficiência de vitamina B9 e/ou B12
2. Ácido Metilmalônico
- aumentado quando deficiência de vitamina B12
Por que ocorre o aumento?
1. Homocisteína
- é transformada em Metionina na ativação de folato (B9)
- se não há folato (B9), há acúmulo
2. Ácido Metilmalônico
- transformado em Succinil-CoA pela Vitamina B12
- se não há Vitamina B12, há acúmulo
Qual substância acumulada é neurotóxica?
Ácido Metilmalônico, portanto deficiência de Cobalamina (Vitamina B12) é a única entre elas capaz de gerar alterações neurológicas.
Quais as principais alterações neurológicas?
Variáveis, são exemplos: neuropatia | mielopatia | demência
Qual a alteração neurológica típica de prova?
DIMINUIÇÃO DE SENSIBILIDADE VIBRATÓRIA
As alterações neurológicas são reversíveis?
Se diagnóstico precoce e reposição vitamínica adequada sim.
Ácido Fólico (Vitamina B9):
Onde ocorre a absorção?
Qual a duração dos estoques?
Quais as principais causas de deficiência? (6)
Como fazer a reposição quando deficiente?
Onde ocorre a absorção?
Duodeno e jejuno, ou seja, intestino delgado proximal.
Qual a duração dos estoques?
Cerca de 3 meses.
Quais as principais causas de deficiência?
1. Baixa ingesta de folhas verdes
- principalmente: alcoolistas, crianças
2. Gestação
- aumento da demanda
3. Hemólise crônica
- aumento da demanda
4. Doença celíaca
- queda da absorção em intestino delgado proximal
5. Fenitoína
- queda na absorção
6. Metotrexate
- queda na ativação em ácido folínico
Como fazer a reposição quando deficiente?
Ácido Fólico via oral 4-5 mg/dia
Cobalamina (Vitamina B12):
Como ocorre a sua absorção?
O que pode impedir a sua absorção, portanto? (4)
Onde ocorre a produção de fator intrínseco?
Quais as principais causas de deficiência? (6)
- Qual A PRINCIPAL causa de deficiência?
Como é feita a reposição de Cobalamina?
Como ocorre a sua absorção?
- COBALAMINA NUNCA FICA SOZINHA:
1. Cobalamina chega ao estômago ligada a proteínas
2. Ácido gástrico cliva essa ligação
3. Cobalamina se liga ao Ligante R (que faz parte da saliva deglutida)
4. No duodeno, em meio básico, enzimas pancreáticas clivam essa ligação
5. Cobalamina se liga ao Fator Intrínseco (FI)
6. Cobalamina + FI são absorvidos em íleo terminal
O que pode impedir a sua absorção, portanto?
1. Falta de ácido gástrico para clivagem da ligação entre cobalamina e proteínas
2. Falta de enzimas pancreáticas para clivagem da ligação entre cobalamina e ligante R
3. Falta de fator intrínseco
4. Distúrbio na absorção a nível de íleo terminal
Onde ocorre a produção de fator intrínseco?
Nas células PARIETAIS de fundo gástrico.
Quais as principais causas de deficiência?
1. Baixa ingesta de proteínas de origem animal
- Vegetarianos / veganos
2. Anemia perniciosa
- doença autoimune com autoanticorpos que atacam células parietais, gerando queda de fator intrínseco
3. Gastrectomias
- como a cirurgia bariátrica
4. Insuficiência pancreática exócrina
- queda nas enzimas pancreáticas
5. Doença de Chron ou Tuberculose intestinal
- gerando ileíte distal e queda na absorção
6. Diphyllobothrium latum
Qual a principal causa de deficiência?
ANEMIA PERNICIOSA
Como é feita a reposição de Cobalamina?
Via PARENTERAL, justamente pela perniciosa ser a causa mais comum e não haver fator intrínseco para absorção.
Anemia Perniciosa:
Definição
Importância epidemiológica
Por que há a anemia?
Quais as principais doenças autoimunes associadas?
Como é feito o tratamento?
Definição: anemia do tipo megaloblástica que ocorre por doença autoimune que ataca células PARIETAIS de fundo gástrico e gera queda de FATOR INTRÍNSECO.
Importância epidemiológica:
PRINCIPAL CAUSA de anemia megaloblástica.
Por que há a anemia?
Pois para haver absorção de cobalamina é necessário que esta esteja ligada ao fator intrínseco, deficiente nesses casos.
Quais as principais doenças autoimunes associadas?
1. Tireoidite de Hashimoto
2. Doença de Graves
Como é feito o tratamento?
Reposição de Cobalamina via PARENTERAL.